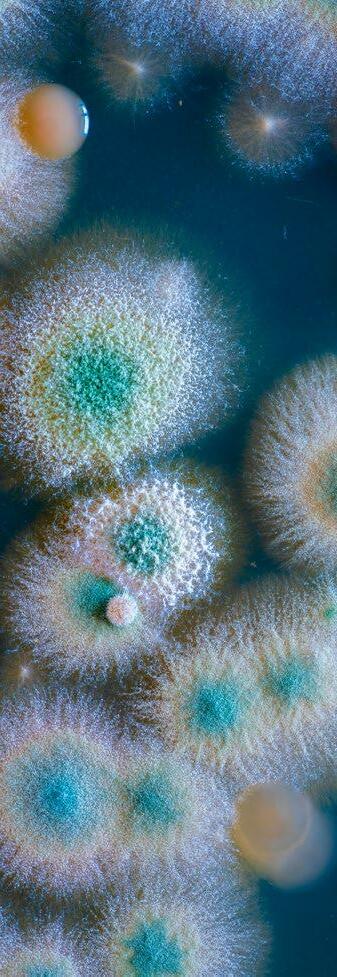

Aditivos de origen vegetal para piensos frente a las micotoxicosis
Entre las diferentes estrategias utilizadas para hacer frente a los desafíos de las micotoxinas en la acuicultura, se encuentra el concepto de aditivos para piensos de origen vegetal.
Las plantas muestran una variedad de aceites esenciales, especias, hierbas y otros extractos que pueden desempeñar un noble papel en la mitigación de los efectos sobre la salud causados por las micotoxinas (Gowda et al., 2013)
Se consideran productos ecológicos, disponibles y asequibles para hacer frente no solo a las micotoxinas, sino también a muchos otros problemas en las industrias de piensos y alimentos (Iram et al., 2016).
En los últimos años, se ha descubierto que los compuestos derivados de las plantas, las cumarinas y los flavonoides, inhiben el efecto cancerígeno de las aflatoxinas (Lee et al., 2001).
También se ha informado de que la curcumina, el ingrediente bioactivo de la cúrcuma, tiene un efecto curativo contra la aflatoxicosis (Ferreira et al., 2013).
Un estudio realizado por Vijayanandraj et al. (2014) examinó la capacidad de degradación de varios extractos de plantas y concluyó que también mostraban la mayor tasa de degradación de aflatoxinas (alrededor del 98%).
También se ha informado de que el aceite extraído de Chenopodium ambrosioides es un inhibidor tanto de las aflatoxinas como de las micotoxinas de Fusarium (Sandosskumar et al., 2007).
Abdelhiee et al. (2020) realizaron un estudio de cuatro semanas para examinar cómo el 0,5-1% de Moringa oleifera mitiga los impactos adversos inducidos por 1 mg/ kg de AFB1 en el crecimiento, la respuesta inmunitaria y los índices bioquímicos y hematológicos de la tilapia del Nilo.
Los exámenes necroscópicos de los grupos alimentados con dietas con aflatoxinas pero sin moringa dieron como resultado un rendimiento de crecimiento inferior (aumento de peso, tasa de crecimiento específica, etc.), bioquímica sérica (glóbulos rojos y blancos, hemoglobina, hematocrito y albúmina), enzimas antioxidantes (superóxido dismutasa y catalasa), así como un aumento significativo de las enzimas hepáticas.
En el examen histopatológico de los grupos alimentados con piensos que contenían aflatoxinas, se detectó dilatación vascular, congestión e hígado necrótico, así como falta de integridad en los intestinos y lesiones en las branquias. Además, cuando se complementó la Moringa oleifera con las dietas de este experimento, se obtuvieron mejoras significativas en el crecimiento, los índices bioquímicos séricos, la histomorfología de los tejidos, la expresión génica y el sistema inmunitario.
La Tabla 1 resume los estudios recientes sobre la aplicación de estrategias físicas, biológicas y microbianas para mitigar los efectos adversos inducidos por la micotoxicosis en una variedad de animales acuáticos.
14
Tabla 1. Estudios sobre la aplicación de estrategias físicas, biológicas y microbianas para mitigar los efectos adversos inducidos por la micotoxicosis en la acuicultura.
Especies Micotoxina y su concentración Agente detoxificante de micotoxinas y su concentración Duración Efecto de mitigación de la(s) sustancia(s) detoxificante(s) de micotoxinas utilizada(s) Referencia
Tilapia del Nilo AFB1 (10-40 mg/kg)
Tilapia del Nilo AFB1 (2-4 mg/ kg)
Bentonita sódica tailandesa (1%) 16 semanas Mejoras en el rendimiento y en la histomorfología de los tejidos (branquias, hígado e intestino).
Neeratanaphanand Tengjaroenkul(2018)
Arcilla bentonita cálcica (0,5 y 10%) 10 semanas Mejora significativa de las tasas de crecimiento. Hussain et al. (2017a)
Tilapia del Nilo OTA (1 mg/kg) Silicatos de aluminio y sodio hidratados (0,2-0,5 g/kg) 6 semanas Protección frente a efectos histopatológicos anormales, mantenimiento de un rendimiento de crecimiento estable y promoción de parámetros bioquímicos saludables.
Tilapia del Nilo AFB2 (2,5 mg/ kg) Silicato de aluminio y sodio hidratado (0,5%) 42 días
Tilapia del Nilo AFB1 (3 mg/kg) Partículas de nanozeolita (5-10 g/kg)
Reducción de la tasa de mortalidad del 16%, mejora del rendimiento del crecimiento y de los índices bioquímicos del suero.
12 semanas Aumento de la utilización del alimento, del crecimiento, de la digestión y de las enzimas antioxidantes, así como de las enzimas hepáticas.
Trucha arcoiris AFB1 (5 mg/kg) Partículas de nanozeolita (0,5- 1%) 56 días Aumento de los niveles de proteínas séricas, albúmina y globulina, así como mejora de la histomorfología de los tejidos.
Tilapia del Nilo AFB1 (0,2 mg/ kg) 0,25% de cada uno: S. cerevisiae, aluminosilicatos cálcicos hidratados y glucomanano esterificado
In vitro (experimental) DON (100,2 mg/L) y AFB1 (2 mg/L)
Carbón activado, arcillas de bentonita, productos de celulosa, producto de la pared celular de la levadura
10 semanas Mejora notable del crecimiento, de los parámetros bioquímicos del suero y de la respuesta inmunitaria, así como de la disminución de los residuos de AFB1 en la musculatura de los peces.
No especificado Prevención de la formación de micotoxinas en los piensos acuícolas.
In vitro (experimental) ZEN (0,02mg/L) Bacillus subtilis y Bacillus natto - No especificado 24 horas
Degradación de aproximadamente el 80-100% del ZEN, respectivamente.
Lubina europea ZEN (0,76 mg/ kg) Ajo dietético (30 g/kg) y quitosano (10 g/kg) 28 días Mejora significativa de las medias de glóbulos rojos y blancos, así como de la hemoglobina corpuscular, de la hemoglobina, de las proteínas totales del suero, de la albúmina, de la globulina, de la lisozima y de la resistencia a la mortalidad inducida por ZEN y Vibrio alginolyticus.
Lubina europea ZEN (0,76 mg/ kg) Ajo dietético (30 g/kg) y quitosano (10 g/kg) 28 días
Trucha arcoiris AFB1 (No especificado)
Salmonete gris AFB1 (0,5-1 mg/kg)
Mitigacióndel estrés oxidativo (disminución de las actividades de superóxido dismutasa, catalasa y glutatión peroxidasa y aumento del malondialdehído), la inmunosupresión y las lesiones histopatológicas inducidas por el ZEN.
L. rhamnosus- No especificado 4 semanas Mejora del cortisol, de la enzima fosfato alcalino, de la glucemia y del crecimiento. Reducción de la mortalidad y de la enzima quimotripsina.
L. acidophilus (10 6 CFU/mL) 8 semanas Mejora notable de los parámetros bioquímicos del suero, el estrés oxidativo de las enzimas hepáticas y mejora las lesiones histopatológicas en el hígado y los intestinos.
Fadl et al. (2020)
El-Alim et al. (2017)
Hassaan et al. (2020)
Alinezhad et al. (2020)
Selim et al. (2013)
Kongetal.(2014)
Tinyiroetal.(2011)
Abdel-Tawwab et al. (2020)
Abdel-Tawwab et al. (2021)
Sadeghietal.(2020)
Khalafallaetal.(2022)
Gamba blanca del Pacífico AFB1 (0,5 mg/ kg)
Lactiplantibacillus pentosus (5 × 10 8 CFU/g) 6 semanas Mitigación del retraso del crecimiento inducido por las aflatoxinas, la inmunosupresión y el daño a la microbiota intestinal, y la histomorfología de los tejidos
Fangetal.(202) Tilapia del Nilo AFB1 (1 mg/kg) Moringa oleifera (0,5-1%) 4 semanas Mejora del crecimiento, de los índices bioquímicos séricos, de los antioxidantes y de las enzimas hepáticas.
Abdelhiee et al. (2020)
15
Conclusiones
Se han introducido numerosos mecanismos para eliminar o reducir las micotoxinas en la acuicultura antes o después de que los animales estén expuestos a ellas
Los métodos químicos implican la aplicación de compuestos químicos como el ozono, el hidróxido de sodio, el amoníaco y diferentes ácidos, que se utilizan principalmente para prevenir la formación de micotoxinas en los alimentos.
Los aditivos para piensos de origen vegetal también son muy recomendables, ya que contienen aceites esenciales, hierbas, especias y otros extractos vitales que son eficaces en cierta medida para combatir las micotoxinas.
Aunque los métodos químicos son eficaces para combatir las micotoxinas, producen efectos perjudiciales, ya que dejan residuos y afectan negativamente al sabor y aspecto de los piensos.
Los enfoques físicos afectan a las micotoxinas con diversos métodos como la limpieza, las luces UV, la clasificación y los agentes secuestrantes o adsorbentes. Este último, en particular, se ha convertido en un imán para muchos estudios, y se ha demostrado su eficacia.
Sin embargo, uno de los principales inconvenientes del enfoque físico es la escasa capacidad de adsorción. Por ello, la combinación de diferentes agentes minerales adsorbentes podría ser beneficiosa, pero es necesario realizar futuras investigaciones al respecto.
El enfoque microbiológico se asocia con la aplicación de bacterias comensales, hongos, las enzimas que producen y aditivos para piensos de origen vegetal.
Los macroorganismos son baratos, respetuosos con el medio ambiente y, lo que es más importante, muy eficaces a la hora de degradar o adsorber micotoxinas. Sin embargo, los compuestos producidos cuando se degradan las micotoxinas pueden no ser seguros y se sabe poco sobre cómo esos productos pueden afectar a los animales, una preocupación del enfoque microbiológico.
Por ello, se consideran necesarios los estudios destinados a descubrir los métodos, la dosificación, la duración de la desintoxicación microbiológica y la seguridad de los productos producidos por los microbios
En el futuro, los estudios deberían centrarse también en los efectos sinérgicos de los métodos de diferentes enfoques, como el físico (agentes minerales adsorbentes) y el microbiológico (microbios, enzimas o aditivos para piensos de origen vegetal) en la eliminación de micotoxinas en la acuicultura.
La mayor parte de la bibliografía existente sobre micotoxinas está asociada a las aflatoxinas, aparentemente por su frecuencia de incidencia. Sin embargo, otras clases de micotoxinas en la acuicultura están mal representadas en la literatura. Por lo tanto, los estudios futuros deberían explorar diferentes tipos de micotoxinas, su formación, efectos y estrategias de mitigación.
16
REFERENCIAS
Abdelhiee, E.Y., Elbialy, Z.I., Saad, A.H., Dawood, M.A., Aboubakr, M., El-Nagar, S.H., El-Diasty, E.M., Salah, A.S., Saad, H.M. and Fadl, S.E., 2021. The impact of Moringa oleifera on the health status of Nile tilapia exposed to aflatoxicosis. Aquaculture, 533, 736110.
Abdel-Tawwab, M., Khalifa, E., Diab, A.M., Khallaf, M.A., Abdel-Razek, N. and Khalil, R.H., 2020. Dietary garlic and chitosan alleviated zearalenone toxic effects on performance, immunity, and challenge of European sea bass, Dicentrarchus labrax, to Vibrio alginolyticus infection. Aquaculture International, 28(2), 493-510.
Abdel-Tawwab, M., Khalil, R.H., Diab, A.M., Khallaf, M.A., Abdel-Razek, N., Abdel-Latif, H.M. and Khalifa, E., 2021. Dietary garlic and chitosan enhanced the antioxidant capacity, and immunity, and modulated the transcription of HSP70 and Cytokine genes in Zearalenone-intoxicated European seabass. Fish & Shellfish Immunology, 113, 35-41.
Alinezhad, S., Faridi, M., Falahatkar, B., Nabizadeh, R. and Davoodi, D., 2017. Effects of nanostructured zeolite and aflatoxin B1 in growth performance, immune parameters, and pathological conditions of rainbow trout Oncorhynchus mykiss. Fish & Shellfish Immunology, 70, 648-655.
Alinezhad, S., Tolouee, M., Kamalzadeh, A., Motalebi, A.A., Nazeri, M., Yasemi, M., Shams, G.M., Tolouei, R. and Razzaghi, A.M., 2011. Mycobiota and aflatoxin B1 contamination of rainbow trout (Oncorhynchus mykiss) feed with emphasis to Aspergillus section Flavi. Iranian Journal of Fisheries, 10(3), 363-374.
Arana, S., Dagli, M.L., Sabino, M., Tabata, Y.A., Rigolino, M.G. and Hernandez-Blazquez, F.J., 2011. Evaluation of the efficacy of hydrated sodium aluminosilicate in the prevention of aflatoxin-induced hepatic cancer in rainbow trout. Pesquisa veterinaria brasileira, 31, 751-755.
Avantaggiato, G., Havenaar, R. and Visconti, A., 2004. Evaluation of the intestinal absorption of deoxynivalenol and nivalenol by an in vitro gas trointestinal model, and the binding efficacy of activated carbon and other adsorbent materials. Food and Chemical Toxicology, 42(5), 817-824. Battilani, C.P., 2008. Food mycology-a multifaceted approach to fungi and food. World Mycotoxin Journal, 1(2), 223-224.
Benvindo da Luz, A., & Lins, FAF., 2008. Rochas & minerais industriais: usos e especificações. ed. Rio de Janeiro, RJ: CETEM/MCT.
Brown, K.A., Mays, T., Romoser, A., Marroquin‐Cardona, A., Mitchell, N.J., Elmore, S.E. and Phillips, T.D., 2014. Modified hydra bioassay to evaluate the toxicity of multiple mycotoxins and predict the detoxification efficacy of a clay‐based sorbent. Journal of Applied Toxicology, 34(1), 40-48.
Cao, H., Liu, D., Mo, X., Xie, C. and Yao, D., 2011. A fungal enzyme with the ability of aflatoxin B1 conversion: Purification and ESI-MS/MS identification. Microbiological Research, 166(6), 475-483.
Čolović, R., Puvača, N., Cheli, F., Avantaggiato, G., Greco, D., Đuragić, O., Kos, J. and Pinotti, L., 2019. Decontamination of mycotoxin-contamina ted feedstuffs and compound feed. Toxins, 11(11), p.617.
Conte, G., Fontanelli, M., Galli, F., Cotrozzi, L., Pagni, L. and Pellegrini, E., 2020. Mycotoxins in feed and food and the role of ozone in their detoxification and degradation: An update. Toxins, 12(8), p.486.
Daković, A., Kragović, M., Rottinghaus, G.E., Sekulić, Ž., Milićević, S., Milonjić, S.K. and Zarić, S., 2010. Influence of natural zeolitic tuff and organozeolites surface charge on sorption of ionizable fumonisin B1. Colloids and Surfaces B: Biointerfaces, 76(1), 272-278.
Di Gregorio, M.C., Neeff, D.V.D., Jager, A.V., Corassin, C.H., Carão, Á.C.D.P., Albuquerque, R.D., Azevedo, A.C.D. and Oliveira, C.A.F., 2014. Mineral adsorbents for prevention of mycotoxins in animal feeds. Toxin Reviews, 33(3), 125-135.
Diaz, D.E and Smith, T.K., 2005. Mycotoxin sequestering agents: practical tools for the neutralisation of mycotoxins. The Mycotoxin Blue Book: 323-339.
El-Alim, A., Galal, A.A., Mahmoud, S.H. and El-Sayed, W.A., 2017. Comparative ameliorative effect of hydrated sodium calcium aluminosilicate and Saccharomyces cerevisiae (Brewer’s yeast) against toxic impact of aflatoxin B1 in Oreochromis niloticus (Nile tilapia). Zagazig Veterinary Journal, 45(Supp. 1), 210-220.
Fadl, S.E., El-Shenawy, A.M., Gad, D.M., El Daysty, E.M., El-Sheshtawy, H.S. and Abdo, W.S., 2020. Trial for reduction of Ochratoxin A residues in fish feed by using nano particles of hydrated sodium aluminum silicates (NPsHSCAS) and copper oxide. Toxicon, 184, 1-9.
Fang, H., Wang, B., Jiang, K., Liu, M. and Wang, L., 2020. Effects of Lactobacillus pentosus HC-2 on the growth performance, intestinal morphology, immune-related genes and intestinal microbiota of Penaeus vannamei affected by aflatoxin B1. Aquaculture, 525, 735289.
Ferreira, F.D., Kemmelmeier, C., Arrotéia, C.C., da Costa, C.L., Mallmann, C.A., Janeiro, V., Ferreira, F.M.D., Mossini, S.A.G., Silva, E.L. and Machinski Jr, M., 2013. Inhibitory effect of the essential oil of Curcuma longa L. and curcumin on aflatoxin production by Aspergillus flavus Link.
17
Food Chemistry, 136(2), 789-793.
Fruhauf, S., Schwartz, H., Ottner, F., Krska, R. and Vekiru, E., 2012. Yeast cell based feed additives: studies on aflatoxin B1 and zearalenone. Food Additives & Contaminants: Part A, 29(2), 217-231.
Ghasemi, Z., Sourinejad, I., Kazemian, H. and Rohani, S., 2018. Application of zeolites in aquaculture industry: a review. Reviews in Aquaculture, 10(1), 75-95.
Gowda, N.K.S., Swamy, H.V.L.N. and Mahajan, P., 2013. Recent advances for control, counteraction and amelioration of potential aflatoxins in animal feeds. In: Aflatoxins-Recent Advances and Future Prospects, Ed: Mehdi Razzaghi-Abyaneh, Chapter 6., pp.129-140. Published by InTech, Rijeka, Croatia.
Guan, Y., Chen, J., Nepovimova, E., Long, M., Wu, W. and Kuca, K., 2021. Aflatoxin detoxification using microorganisms and enzymes. Toxins, 13(1), p.46.
Hassaan, M.S., Nssar, K.M., Mohammady, E.Y., Amin, A., Tayel, S.I. and El-Haroun, E.R., 2020. Nano-zeolite efficiency to mitigate the aflatoxin B1 (AFB1) toxicity: Effects on growth, digestive enzymes, antioxidant, DNA damage and bioaccumulation of AFB1 residues in Nile tilapia (Oreochromis niloticus). Aquaculture, 523, 735123.
Haskard, C.A., El-Nezami, H.S., Kankaanpää, P.E., Salminen, S. and Ahokas, J.T., 2001. Surface binding of aflatoxin B1 by lactic acid bacteria. Applied and environmental microbiology, 67(7), 3086-3091.
Huang, W.; Chang, J.; Wang, P. 2018b. Effect of the combined compound probiotics with mycotoxin-degradation enzyme on detoxifying aflatoxin B1 and zearalenone. J. Toxicol. Sci. 43, 377–385.
Hussain, D. and Mateen, A., 2017b. Alleviation of aflatoxin-B1 toxicity by using clay adsorbent in Nile tilapia (Oreochromis niloticus) diets. Pakistan Journal of Zoology, 49(2), 425-431.
Hussain, D., Mateen, A. and Gatlin III, D.M., 2017a. Alleviation of aflatoxin B1 (AFB1) toxicity by calcium bentonite clay: Effects on growth performance, condition indices and bioaccumulation of AFB1 residues in Nile tilapia (Oreochromis niloticus). Aquaculture, 475, 8-15.
Hussain, D., 2018. Effect of aflatoxins in aquaculture: use of bentonite clays as promising remedy. Turkish Journal of Fisheries and Aquatic Sciences, 18(8), 1009-1016.
Huwig, A., Freimund, S., Käppeli, O. and Dutler, H., 2001. Mycotoxin detoxication of animal feed by different adsorbents. Toxicology letters, 122(2), 179-188.
Ji, J. and Xie, W., 2021. Removal of aflatoxin B1 from contaminated peanut oils using magnetic attapulgite. Food Chemistry, 339, 128072.
Iram, W., Anjum, T., Iqbal, M., Ghaffar, A. and Abbas, M., 2016. Structural elucidation and toxicity assessment of degraded products of aflatoxin B1 and B2 by aqueous extracts of Trachyspermum ammi. Frontiers in Microbiology, 7, 346.
Kabak, B., Dobson, A.D. and Var, I.I.L., 2006. Strategies to prevent mycotoxin contamination of food and animal feed: a review. Critical reviews in food science and nutrition, 46(8), 593-619.
Kannewischer, I., Arvide, M.G.T., White, G.N. And Dixon, J.B., 2006. Smectite clays as adsorbents of aflatoxin B1: Initial steps. Clay Science, 12 (Supp 2), 199-204
Karlovsky, P., Suman, M., Berthiller, F., De Meester, J., Eisenbrand, G., Perrin, I., Oswald, I.P., Speijers, G., Chiodini, A., Recker, T. and Dussort, P., 2016. Impact of food processing and detoxification treatments on mycotoxin contamination. Mycotoxin Research, 32(4), 179-205.
Khalafalla, M.M., Zayed, N.F., Amer, A.A., Soliman, A.A., Zaineldin, A.I., Gewaily, M.S., Hassan, A.M., Van Doan, H., Tapingkae, W. and Dawood, M.A., 2022. Dietary Lactobacillus acidophilus ATCC 4356 Relieves the Impacts of Aflatoxin B1 Toxicity on the Growth Performance, Hepatorenal Functions, and Antioxidative Capacity of Thinlip Grey Mullet (Liza ramada)(Risso 1826). Probiotics and Antimicrobial Proteins, 14(1), 189-203. Kolosova, A. and Stroka, J., 2011. Substances for reduction of the contamination of feed by mycotoxins: A review. World Mycotoxin Journal, 4(3), 225-256.
Kong, C., Shin, S.Y. and Kim, B.G., 2014. Evaluation of mycotoxin sequestering agents for aflatoxin and deoxynivalenol: an in vitro approach. SpringerPlus, 3(1), 346.
Lee, S.E., Campbell, B.C., Molyneux, R.J., Hasegawa, S. and Lee, H.S., 2001. Inhibitory effects of naturally occurring compounds on aflatoxin B1 biotransformation. Journal of Agricultural and Food Chemistry, 49(11), 5171-5177.
Li, C.H., Li, W.Y., Hsu, I.N., Liao, Y.Y., Yang, C.Y., Taylor, M.C., Liu, Y.F., Huang, W.H., Chang, H.H., Huang, H.L. and Lo, S.C., 2019. Recombinant aflatoxin-degrading F420H2-dependent reductase from mycobacterium smegmatis protects mammalian cells from aflatoxin toxicity. Toxins, 11(5), 259.
18
Nathanail, A.V., Gibson, B., Han, L., Peltonen, K., Ollilainen, V., Jestoi, M. and Laitila, A., 2016. The lager yeast Saccharomyces pastorianus removes and transforms Fusarium trichothecene mycotoxins during fermentation of brewer’s wort. Food Chemistry, 203, 448-455.
Neeratanaphan, L. and Tengjaroenkul, B., 2018. Protective effects of Thai bentonite on aflatoxin B1 contaminated in diet of tilapia fish. Livestock Research for Rural Development, 30(8), 152.
Rahaie, S., Emam‐Djomeh, Z., Razavi, S.H. and Mazaheri, M., 2012. Evaluation of aflatoxin decontaminating by two strains of Saccharomyces cerevisiae and Lactobacillus rhamnosus strain GG in pistachio nuts. International Journal Of Food Science & Technology, 47(8), 1647-1653.
Sadeghi, N., Bahadori, R., Ojagh, S.M. and Salamroodi, E., 2020. Effect of dietary Lactobacillus rhamnosus on blood biochemical indices and some digestive enzymes activity in rainbow trout (Oncorhynchus mykiss) fed with aflatoxin B1 infected diet. Journal of Animal Environment, 12(2), 151-160.
Sandosskumar, R., Karthikeyan, M., Mathiyazhagan, S., Mohankumar, M., Chandrasekar, G. and Velazhahan, R., 2007. Inhibition of Aspergillus flavus growth and detoxification of aflatoxin B1 by the medicinal plant zimmu (Allium sativum L.× Allium cepa L.). World Journal of Microbiology and Biotechnology, 23(7), 1007-1014.
Sava, S.C., Pogurschi, E., Bahaciu, G.V., Dragomir, N. and Nicolae, C.G., 2019. The effects of clinoptilolite from feed upon fish rearing and water quality. Current Trends in Natural Sciences, 8(16), 212-219.
Selim, K.M., El-hofy, H. and Khalil, R.H., 2014. The efficacy of three mycotoxin adsorbents to alleviate aflatoxin B1-induced toxicity in Oreochromis niloticus. Aquaculture International, 22(2), 523-540.
Shaban, M., AbuKhadra, M.R., Nasief, F.M. and El-Salam, A., 2017. Removal of ammonia from aqueous solutions, ground water, and wastewater using mechanically activated clinoptilolite and synthetic zeolite-a: kinetic and equilibrium studies. Water, Air, & Soil Pollution, 228(11), 1-16.
Taheur, F.B., Fedhila, K., Chaieb, K., Kouidhi, B., Bakhrouf, A. and Abrunhosa, L., 2017. Adsorption of aflatoxin B1, zearalenone and ochratoxin A by microorganisms isolated from Kefir grains. International Journal of Food Microbiology, 251, 1-7.
Tapia Salazar, M., García-Pérez, O.D., Nieto López, M., Ricque Marie, D., Villarreal Cavazos, D. and Cruz Suárez, L.E., 2010. Mycotoxins in aquaculture: Occurrence in feeds components and impact on animal performance. In: Avances en Nutrición Acuícola X-Memorias del Décimo Simposio Internacional de Nutrición Acuícola (pp.8-10).
Tinyiro, S.E., Wokadala, C., Xu, D. and Yao, W., 2011. Adsorption and degradation of zearalenone by bacillus strains. Folia Microbiologica, 56(4), 321-327.
Vekiru, E., Fruhauf, S., Sahin, M., Ottner, F., Schatzmayr, G. and Krska, R., 2007. Investigation of various adsorbents for their ability to bind aflatoxin B1. Mycotoxin Research, 23(1), 27-33.
Vijayanandraj, S., Brinda, R., Kannan, K., Adhithya, R., Vinothini, S., Senthil, K., Chinta, R.R., Paranidharan, V. and Velazhahan, R., 2014. Detoxification of aflatoxin B1 by an aqueous extract from leaves of Adhatoda vasica Nees. Microbiological Research, 169(4), 294-300.
Vila-Donat, P., Marín, S., Sanchis, V. and Ramos, A.J., 2018. A review of the mycotoxin adsorbing agents, with an emphasis on their multi-binding capacity, for animal feed decontamination. Food and Chemical Toxicology, 114, 246-259.
Wagner, S., Gondikas, A., Neubauer, E., Hofmann, T. and von der Kammer, F., 2014. Spot the difference: engineered and natural nanoparticles in the environment—release, behavior, and fate. Angewandte Chemie International Edition, 53(46), 12398-12419.
Wielogórska, E., MacDonald, S. and Elliott, C.T., 2016. A review of the efficacy of mycotoxin detoxifying agents used in feed in light of changing global environment and legislation. World Mycotoxin Journal, 9(3), 419-433.
Yu, Y., Shi, J., Xie, B., He, Y., Qin, Y., Wang, D., Shi, H., Ke, Y. and Sun, Q., 2020. Detoxification of aflatoxin B1 in corn by chlorine dioxide gas. Food Chemistry, 328, 127121.
Zahran, E., Risha, E., Hamed, M., Ibrahim, T. and Palić, D., 2020. Dietary mycotoxicosis prevention with modified zeolite (Clinoptilolite) feed additive in Nile tilapia (Oreochromis niloticus). Aquaculture, 515, 734562.
Zaid, A.M.A., 2017. Biodegradation of aflatoxin by peroxidase enzyme produced by local isolate of Pseudomonas sp. Int J Sci Res Manag, 5, 7456-7467.
Zhou, J., Tang, L., Wang, J. and Wang, J.S., 2018. Aflatoxin B1 disrupts gut-microbial metabolisms of short-chain fatty acids, long-chain fatty acids, and bile acids in male F344 rats. Toxicological sciences, 164(2), 453-464.
Zychowski, K.E., Hoffmann, A.R., Ly, H.J., Pohlenz, C., Buentello, A., Romoser, A., Gatlin, D.M. and Phillips, T.D., 2013. The effect of aflatoxin-B1 on red drum (Sciaenops ocellatus) and assessment of dietary supplementation of NovaSil for the prevention of aflatoxicosis. Toxins, 5(9), 1555-1573.
19